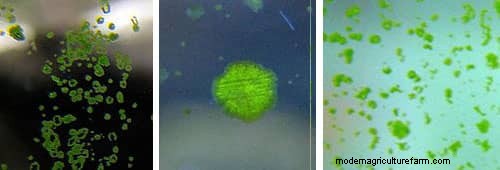
Types of Algae. Best Algae Eating Team

Sooner or later, no matter how hard we try, but every aquarium gets algae. There is no way around it, especially if you are going for a planted tank and you are running highlights. In general, algae are harmless other than the fact that it will make your tank look really horrible. Therefore, if you do not want to clean it all the time you will need some help. Lucky us, there are wonderful aquatic creatures who can eat different types of algae and they can do it as a team. Let’s take a look at the best algae eating team.
Otocinclus fish, Amano shrimp, and Nerite snails will be your vanguard force against algae. This algae eating crew will take care of it for you in absolute majority cases. And what is the most important part here – they are peaceful creatures and can be kept together without problems.
I bet that you have already seen some other articles on the Internet about the best algae eaters. Well, guess what, in most cases, all these top 5, top 10, etc eaters cannot coexist with each other for a prolonged period of time due to predatory nature. Second, some of them eat algae only when they are young. Third, in most cases, it isn’t possible to keep them in small tanks. Fourth, people just list them without providing any additional information regarding algae-eating preferences.
This is not our case. We need to know details and I would like to repeat it once again that this time we are creating a clean-up crew. In this way, they can compensate for each other’s weaknesses and strengthen their qualities. We do not want our shrimp, snail, or fish got eaten and we want them to work tirelessly day by day 24/7.
However, before we start, we need to know more about algae in our tanks.
Algae are single or multicellular organisms that have no roots, stems or leaves and have primitive methods of reproduction. Algae can live in a wide range of aquatic environments and are a natural component of most aquatic ecosystems.
It can be broken down into seven groups and within those groups, there are several thousand species and over 700 common types. The number is huge!
Now, it becomes obvious why we need to combine fish, shrimp, and snail. Each of them cannot deal with all types of algae but together they will eat the most common algae in our tanks, which are:
These are small, circular green spots, which you can see on your glass, plant, driftwood, rocks, and even substrate. These types of algae do not grow tall. Green spot algae are hard to remove (the harder the water, the harder you will find it to remove the spots). For example, if you decide to do it yourself, you will need a razor blade, scrapper, or blade cleaner for this work.
Potential cause: too much light, low phosphate levels, low or fluctuating CO2, and poor water flow.
Read more about it in my articles:
CO2 in a Shrimp Tank
CO2 in a Planted Tank Guide
Who can eat Green spot algae: Nerite snails. Amano shrimp can also greatly contribute unless these algae grow on the glass.
You can read more about it in my article “How to Remove Green Spot Algae in Aquariums”.

Basically, it looks like a layer of loose dust. Unlike Green spot algae, this type of algae can be wiped off the aquarium glass with a finger. In some cases, you can even remove it with water flow. However, this is only in the beginning. Later, Green dust algae can cement itself and become really hard.
Potential cause: too much light, not enough nutrients, low or fluctuating CO2, common on new setups.
Who can eat Green dust algae: Nerite snails, Otocinclus fish. Amano shrimp (although they cannot clean the glass).

These are a large group of multicellular algae (class of about 1,500 species of algae in the division Chromophyta). Brown algae are tiny little animals called diatoms, which cannot be seen without a microscope.
This is the first algae that technically you are going to find in your tanks because it is present in most tanks that are cycling. It is a sign of poor water quality in your tank. Generally, this problem resolves itself over time.
Potential cause: common on new setups because of silicates and ammonia spikes.
Who can eat Brown/Diatomic algae: Otocinclus fish are the best for this job. Next, Nerite Snails. Amano shrimp can also eat brown algae. However, they will not be able to clean the glass in your tank. They simply do not have the necessary tools for that. It is really hard for shrimp to clean spots.

These algae have the appearance of string, beards, brush bristles or tufts. This is one of the most well-known types of algae to show up in the tank. Hair algae can grow at an impressive speed. Without proper management, it will cover your entire tank in no time. These algae attach themselves with holdfast organs. However, the attachment is not strong and you can use a toothbrush to easily remove hair algae.
Potential cause: too much light, not enough nutrients, low or fluctuating CO2, ammonia spikes.
Who can eat Hair algae: Amano shrimp, Nerite snails.
You can read more about it in my article “How to Remove Hair Algae in Aquariums”.

They look like short shaving brushes of dark-colored tufts. These algae are very resistant and also grow pretty fast. In addition, it is difficult to remove black beard algae because of how firmly it attaches itself.
Potential cause: too much light, low or fluctuating CO2, bad water filtration, overfeeding.
Who can eat Black beard algae: Amano shrimp. Nerite snail can only eat dead black beard algae.
Note: There are some reports that Ramshorn snails (guide about this snail) and Siamese Algae eaters will eat Black beard algae. Do not feed the snails anything during this time, keep them hungry. You want them to eat the algae only.
You can read more about it in my article “How to Remove Black Beard Algae in Aquariums”.

There are more than 7,000 species of red algae (Approximately 5% (~350 species) of the red algae occur in freshwater environments). They can be red, reddish, purplish, or reddish-purple in color. Technically, Red algae are not plants, although like plants they use chlorophyll for photosynthesis and they have plant-like cell walls. These algae are protists or microscopic and range from simple one-celled organisms to complex multi-celled organisms.
Potential cause: too much/low light, low CO2, accumulation of nutrients, ammonia, bad water circulation.
Who can eat Red algae: Amano shrimp.

Staghorn algae grow in strands that branch out and look a bit like deer antler. These algae show up in various shades of gray. However, it belongs to the group of red algae. If you take a piece of it and dip it in alcohol, it will turn red indicating it is of the red algae family. They are hard to remove manually.
Sometimes people confuse Staghorn algae and Black beard algae. In order to see the difference, you need to look looking at the growth pattern. Black beard algae grow in shorter tufts, while staghorn algae threads can attain a longer and bushier appearance.
Potential cause: too much/low light, low CO2, accumulation of nutrients, ammonia, bad water circulation.
Who can eat Staghorn Algae: None will touch it.
Note: Amano shrimp are the only ones who can eat Red algae (Staghorn belongs to the group of red algae). Therefore, theoretically, they should eat it if they are very hungry.
You can read more about it in my article “How To Remove Staghorn Algae In Aquariums”.

This is a unicellular alga. It is quite easy to recognize it because the water in the tank goes cloudy. Sometimes it can be like a green tint, in other cases, it can look like pea soup.
These green algae usually are in the genera Chlorella, Ankistrodesmus, and Scenedesmus. Green water algae float freely in the water and do not settle on surfaces like the glass, decoration, or equipment in the tank.
Potential cause: ammonia, low CO2, too much light.
Who can eat Green water algae: Unfortunately, these algae are too small for Nerite snail and Otocinclus fish. However, Bamboo shrimp, due to the unique food intake technique, can easily eat free-floating algae and microorganisms.
You can read more about this wonderful shrimp in my article “Bamboo shrimp – Detailed Guide: Care, Diet and Breeding”.
I would have never believed if anyone would have told me that Amano shrimp can also use the unique food intake technique of Bamboo shrimp! I bet that you have never heard about it before as well. However, this is true. Simply look at this video.
Read more about it in my article “Green Water Algae Profile and How to Remove”.

Actually, this is a bacteria, which obtain their energy with the help of photosynthesis. These algae are better known as “pond scam”. A large infestation can become a real problem for the tank, as the cyanobacteria leave the water low in oxygen. In addition, some types of cyanobacteria can be toxic for your fish, shrimp or snails.
It has a distinctive musty smell that can sometimes be noticeable even walking near the tank. It can be easily wiped manually or using sithon.
Interesting fact #1: They are the oldest known fossils, more than 3.5 billion years old.
Interesting fact #2: The Aztecs consumed these algae frequently. Current studies proved that these “algae” contain a lot of protein and other substances that promote body health and can help against chronic diseases.
Potential cause: too much/low light, ammonia spikes, new setups, bad water circulation.
Who can eat Blue-Green Algae: None will touch it.
Technically, these are not algae and nobody eats this bacteria. You will have to use chemicals such as hydrogen peroxide, etc.
If we summarize all factors known to trigger algae in our aquariums, we will get:
Unfortunately, nobody knows for sure the exact combination of factors that can cause algae blooms. These factors are not yet well understood.
Good for: green algae, green dust algae, brown/diatoms, plant and glass cleaning.
Adult size: 1.5 – 2 inches (3.8 – 5 cm)
Minimal tank size: 10 gallons for 1 – 3 fish
Minimal pack size: prefer to be kept in small schools of 3-5 fish
Otocinclus Catfish are most known as an Otto Cats, Dwarf suckermouths, or algae scrapers. They are considered as one of the best algae eaters for small tanks. This is a very attractive fish and it should be kept only with peaceful tank mates like shrimp and snails.
Otocinclus Catfish will eat lots of varieties of algae. However, according to multiple reports, brown algae are their personal favorite.
Unfortunately, these fish are sensitive to poor water quality (so they might not be the best choice for beginners). Therefore, it will be better to add them to a tank with an already established environment.
They do amazing in groups. Basically, these fish will be vacuum cleaners in your tank. They constantly graze of algae. It is the main part of their diet. And what is more important, they do ignore other food and love algae.
If you run out of algae (congratulations by the way!), you can supplement their diet with algae wafers (link to check the price on Amazon) to ensure they have plenty to eat.
Note: It is easy to confuse Otocinclus fish with Chinese Algae Eater (CAE), Siamese Algae Eater (SEA), and Siamese Flying Fox. Actually, they do look a lot alike at first glance. However, Otocinclus fish have a shorter body compared to the others listed maxing out at 2 inches long in most cases.
You can read more about Otocinclus Catfish in my detailed guide.
Good for: green algae, green dust algae, green spots, algae brown/diatoms, hair algae.
Adult size: 1 inch (~2,5 – 3 cm)
Minimal tank size: 2,5 gallons (~10 liters)
Minimal pack size: solitary
Nerite Snails are the most beautiful snails in aquatic hobby. They look simply amazing. However, this is not the only reason why they are in such great demand. They are definitely the most popular choice when it comes to algae eating snails.
Nerite snails will be fascinating to watch moving through your tank eating algae off of the hard surface and possibly some leftover food lying on the bottom of the tank.
These tireless, relentless eaters will not stop cleaning your aquarium. Nerite snails have an appetite for green spot algae. Whether it is on your glass, plants, driftwood, or rocks, they will hunt it down and eat it up.
Note: Green spot algae are hard for most algae eaters, in most cases, they usually give up and look for something easier. Nerite snails will not have problems with that.
Like all snails, Nerite snails consume a lot and poop quite a bit. It means that they add lots of bioload to the tank. Generally, it is not good for the water quality and if your filtration cannot keep up with all the poop, expect some problems (for example, ammonia spike). However, because of our team, you will get a positive effect.
All your shrimp will like it. The snails’ poop has bacteria that is good for the digestive system of the shrimp. You can also read my article how shails benefit shrimp tank right here.
You can read more about Nerite snails in my detailed guide.
Good for: green algae, red algae, green dust algae, green spots, algae brown/diatoms, hair algae, black beard algae. Basically, almost every type of algae found in a freshwater aquarium, including the harder to eradicate ones such as Green Spot Algae, Black beard algae, and Green beard algae.
Adult size: 1.5 – 2″ (3 – 6 cm)
Minimal tank size: 2.5 gallons (~10 liters)
Minimal colony size: 5 – 6 shrimp
Amano Shrimp were introduced to the hobby and made popular in the early 90s by the late great aquarist Takashi Amano. Various forums on the internet were spreading the good news of the fantastic capacity of this particular shrimp to consume algae. The news has even spread to science as scientists are using the Amano shrimp to control the undesired growth of epiphytic algae nowadays.
Amano shrimp are amazing. They are constantly going to be eating away algae and detritus in your tank.
I cannot praise enough these shrimp. First of all, Amano shrimp are one of the hardiest in shrimp keeping hobby (you can read my article “3 Most Hardy Dwarf Shrimp For Beginners”). Therefore, this type of shrimp is perfect for beginner tanks since they are easily adaptable to various tank environments.
Second, Amano shrimp are the best algae-eating shrimp species. Although all shrimp enjoy algae as a part of their diet (For example, in the wild, according to studies, shrimp feed on algae, biofilm, and detritus. Algae were found in 65% in shrimp guts), they are no match for Amano shrimp. Amano shrimp are in a league of their own.
This is an example of how Amano shrimp deal with algae.
In my guide about Amano shrimp, I mentioned an interesting experiment – who is the best green algae eater?
Well-fed Amano shrimp, Cherry shrimp, Nerite snails, and fish were fasted for 48 hours to produce a similar starting point for all types of grazing animals. Then, Amano shrimps, fish, and snails were left to graze on the tiles with green algae for a period of time before the tiles were removed and analyzed.
The result was obvious. Amano shrimp were the most efficient algae grazers on the type of substrate offered in that experiment. When the grazing was expressed as the rate per animal, Amano shrimp was
When the grazing was expressed as per weight (g), the Amano shrimp was
In addition, the study was very conclusive in the sense that Amano shrimp removes much more algal biomass per time unit. Amano shrimp is the best algal-eater among all the candidates. Hail the King!
If you plan to keep algae eating shrimp, Amanos are definitely your best option.

You can read more about it in my article “Сherry Shrimp in a Community Tank. Tips to Make it Successful”.
Read my article “Step-by-Step Cycling your Shrimp Aquarium Fishless”.
To prevent more algae growth, make sure:
Warning: if you have shrimp in your tank, DO NOT overdose. According to the manufacturer, I quote “When dosed as instructed, Flourish Excel (and all of the Flourish products) is safe for shrimp”.
Amano shrimp, Nerite snail, and Otocinclus Catfish are great algae eaters. Together they will do a phenomenal job and multiply the effect by 10 times. They are the best algae eating team you can wish for.
Nonetheless, despite their amazing abilities, you have to understand that shrimp/fish keeping hobby also has some rules, and if you do not follow them nothing will help you.
Shrimp, snails or fish are more like a rescue team. They can eat algae but cannot fix the cause of algae problems in your aquarium. That is why if you keep getting lots of algae in your tanks, you need to get to the root of the problem.